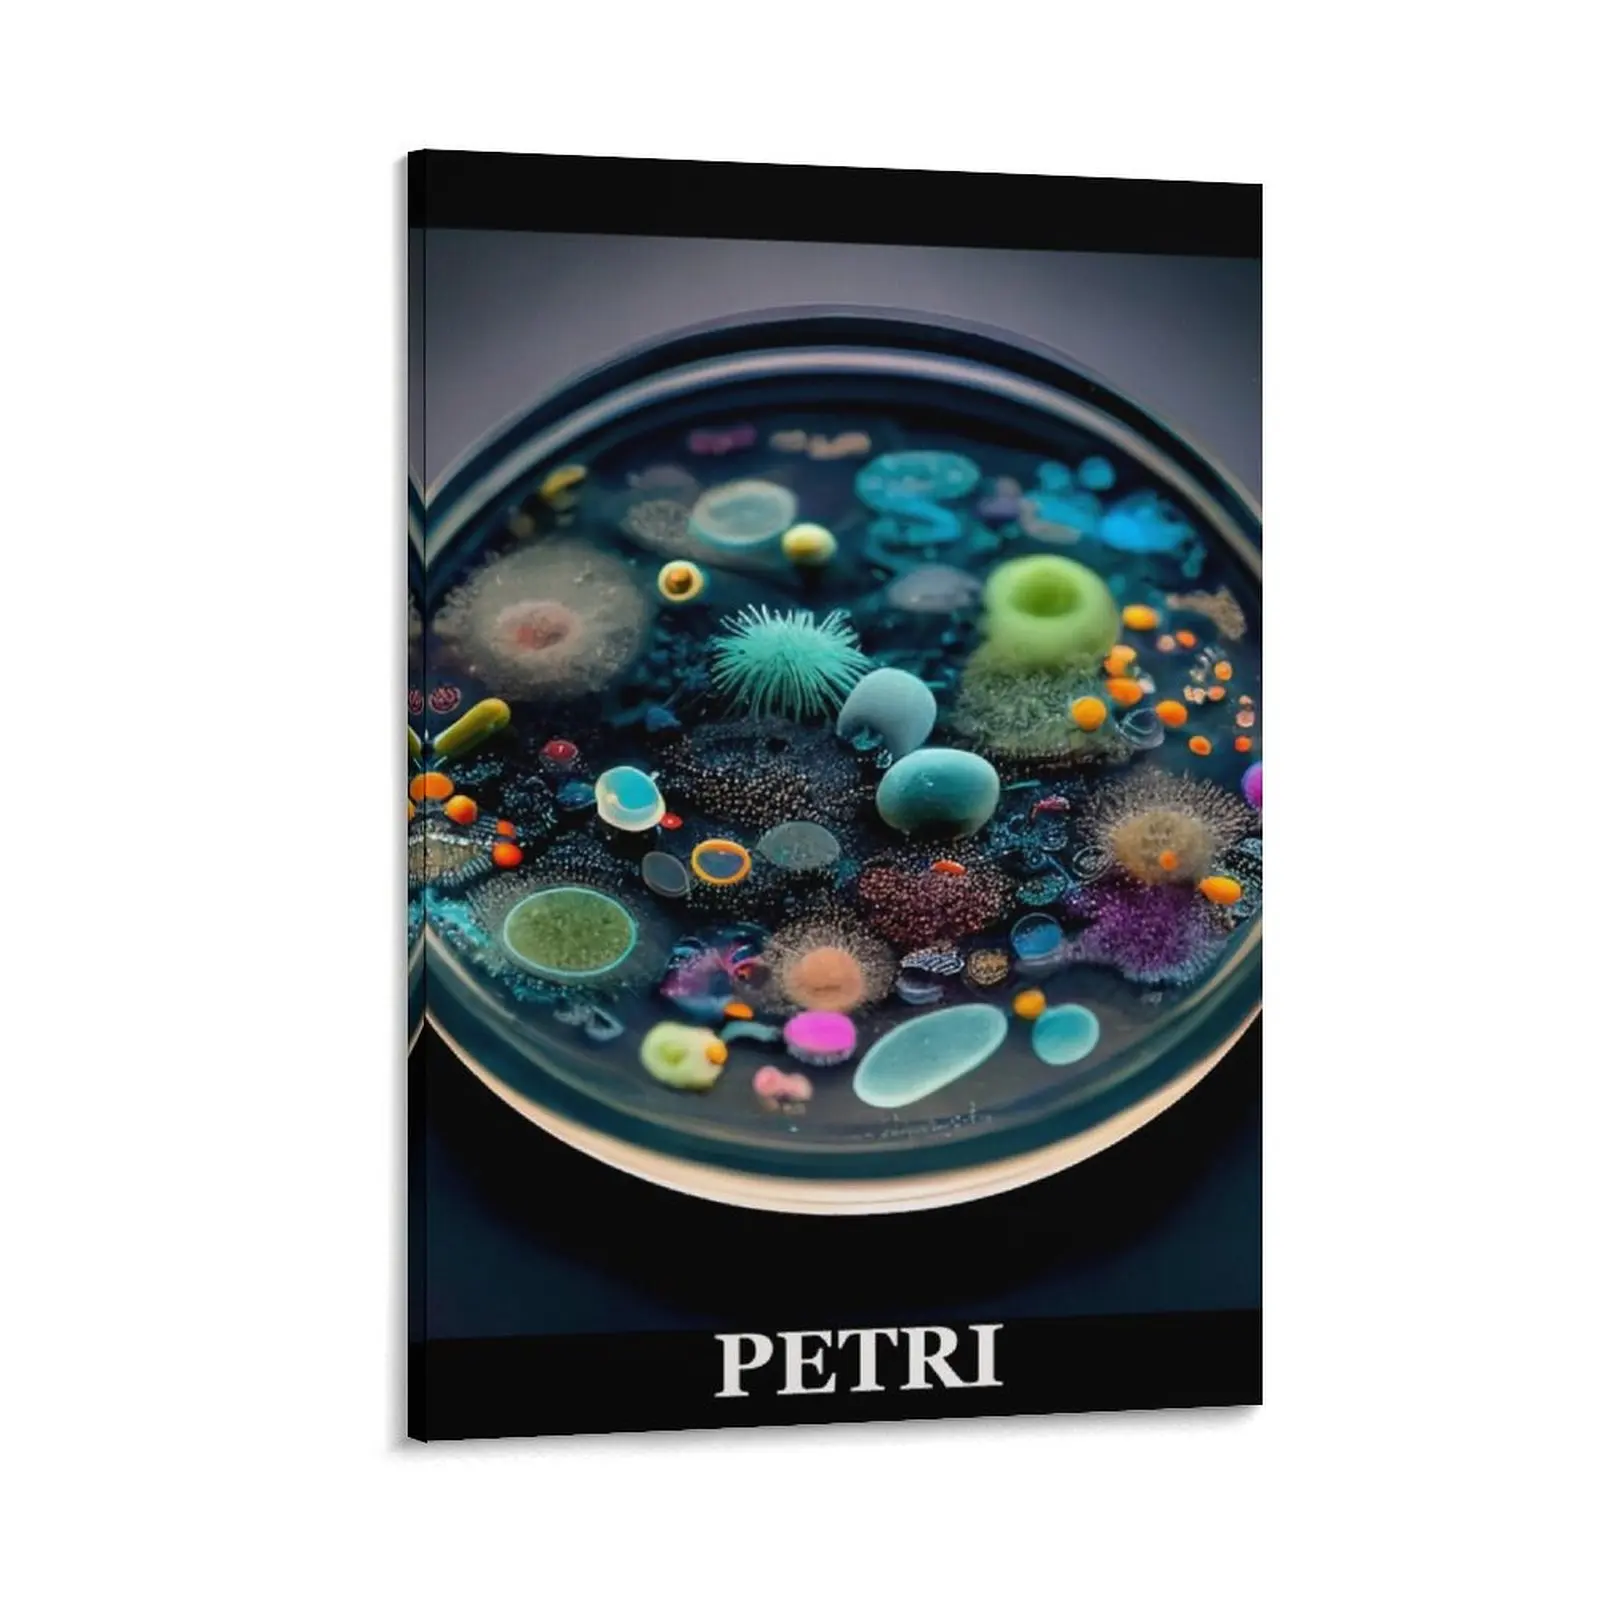

316 нержавеющая сталь термокружка модная соломенная бутылка прочная кофейная кружка мужская жёлтый
Price history chart & currency exchange rate
Customers also viewed

1,799.06 руб.
iSaprio Flip pouzdro Ornamental Flowers 03 pro Xiaomi Redmi Note 14 Pro 5G/14 Pro+ 5G
alza.cz
3,194.47 руб.
Удобный сенсорный смеситель для раковины, цифровой экран, медная конструкция, смеситель для горячей и холодной воды и очистка
aliexpress.ru
1,020.83 руб.
Винтовой ключ для масляного фильтра мотоцикла, наконечник 76 мм, черный для Sportster 883 Touring Street Glide Road Glide FXDB
aliexpress.ru
1,192.73 руб.
(10 шт.) новый оригинальный чип CD74HC123M96 CD74HC123M, продажа и переработка IC
aliexpress.ru
43,069.53 руб.
Металлический табурет в скандинавском стиле, роскошный современный декоративный стул для гостиной, высокие стулья, домашняя Недорогая кухня
aliexpress.ru
2,756.16 руб.
Профессиональный транспортный подъемник для мебели, набор инструментов, 5 шт., Тяжелые материалы, набор ручных инструментов для перемещения, устройство для перемещения колес
aliexpress.ru
1,152.81 руб.
Petri Dish Canvas Painting wall decoration paintings Decoration for bedroom large paintings modern living room decoration
aliexpress.ru
330.77 руб.
Plush Indoor Slippers Tiger Skins Warm Soft Shoes Home Footwear Autumn Winter
aliexpress.com
1,696.22 руб.
Бренд Tarot, лунное одеяло для кемпинга, одеяло с нитью, одеяло для дивана, индийское одеяло, Походное одеяло для кемпинга на природе
aliexpress.ru
693.32 руб.
LTGEM EVA Hard Storage Travel Carrying Case for Logitech MX Anywhere 2 / 2S Wireless Mobile Mouse Travel Bag
aliexpress.com
34,970.00 руб.
Комплект (стол, 4 стула) TetChair QUADRON (mod. PT14), Стол МДФ/металл, стул металл/велюр, 100х100х73 см, 69х56х71 см, Light-grey (св-серый) HLR-14 черный (21299), QUADRON (mod. PT14), Стол МДФ/металл, стул металл/велюр, 100х100х73 см, 69х56х71 см, Light-
techport.ru
2,198.00 руб.
1/4/6 шт., эластичный чехол из спандекса с принтом, чехол для обеденного стула, современный съемный антигрязный чехол для кухонного сиденья, эластичные чехлы для банкета
joom.ru
1,855.00 руб.
Чехол для переноски Защитная сумка из искусственной кожи Новая сумка для хранения экшн-камеры Insta360 GO3
joom.ru
1,147.00 руб.
2 шт., силиконовая подкладка для фритюрницы, круглая складная, пищевая, не содержит BPA, термостойкая, можно мыть в посудомоечной машине, многоразовая духовка, противень, корзина, миска, кухонные принадлежности
joom.ru
594.00 руб.
Protector Environmental Flame Retardant Organizer Cable Sleeve Heat Shrink Tube Wire Wrap Kit
joom.ru
355.00 руб.
Talos Рождественский олень / Трость / Дерево Бросить Наволочка Подушка Чехол Домашний диван-кровать Декор автомобиля
joom.ru
1,517.00 руб.
Повседневная бейсболка для женщин и унисекс модная шляпа жесткий верх кепки снэпбэк шляпа унисекс
joom.ru
1,754.00 руб.
Цифровой мультиметр BSIDE A1X Усовершенствованный дисплей USB-зарядка Бесконтактное обнаружение напряжения Портативный тестовый измеритель с автоматическим диапазоном
joom.ru
1,121.85 руб.
Air Humidifier Vintage Lamp Night Light Nano Mist Sprayer Aromatherapy Diffuser USB Rechargeable Portable Air Humidifier
aliexpress.com
2,383.84 руб.
Летняя зимняя обувь для собак, водонепроницаемая Теплая Флисовая обувь на молнии, противоскользящая обувь, носки, аксессуары для йоркширск...
aliexpress.ru
248.49 руб.
for Roidmi EVE Plus Robot Vacuum Cleaner side Brush HEPA Filter Cleaning Brushes Replacement Accessories Parts
aliexpress.com
2,187.49 руб.
NEW-14Pcs Center Console Navigation Button Stickers Air Conditioner Adjust Cover Trim Car Interior for Touareg 2011-2015
aliexpress.com
70.88 руб.
Stainless Dual Sided Nail File Metal Grinding Rod Scrub Nail Art File Manicure Pedicure Tool 17.6*0.9cm High Quality
aliexpress.com
2,308.88 руб.
MT30A 2 inch IP67 waterproof motorcycle driving recorder bicycle motorcycle black box driving recorder with parking 360° monitor
aliexpress.com
6,108.68 руб.
60V Lab Power Supply Laboratory Adjustabl Switched Source Voltage Regulator 220v 110v Current Stabilizer Programmable Encoder
aliexpress.com
4,117.53 руб.
SuperAen Suit Women's 2022 Spring Summer New Design Irregular Top+gradient Wide-leg Pants
aliexpress.com
4,073.54 руб.
Knitted or crocheted dress for women, autumn 2021, Korean, elegant, chess, long sleeve, round collar, lasso, plied, midi
aliexpress.com
1,962.63 руб.
2022 Spring New Loose Thin Lazy Style Round Neck Sweater Korean Arrival Casual Simple Solid Color Women Tops Tide Free Shipping
aliexpress.com
1,926.78 руб.
Одеяло Duran, покрывало для кровати, клетчатое покрывало для кровати, аниме плюшевое одеяло с капюшоном, постельное белье и покрывала
aliexpress.com
1,248.95 руб.
Женский слитный Леопардовый порно-костюм большого размера, женское сексуальное нижнее белье, костюм-кошка, одежда для сна
aliexpress.com
3,609.16 руб.
Вертикальная стойка для фена Dyson, стойка для хранения волос без перфорации, подходит для парикмахерской
aliexpress.com
955.65 руб.
Hand-Forged Wrought Iron Metal Rose Heart-Shaped Stand With Lights Valentine's Day Gift Anniversary Gift
aliexpress.com
1,663.60 руб.
baby cute cartoon spring and autumn clothes cotton jacket pants girls outfits, White
dhgate.com
1,302.72 руб.
5XL size women's jeans 2020 autumn new Korean version of slim slimming high waist tight feet elastic pencil pants
aliexpress.com
5,302.93 руб.
HONEST Powerful Jet Torch Lighter Cigar Pipe Jet Turbo BBQ Lighter Free Fix Fire Windproof Spray Gun Metal Gas Lighter 1300 C
aliexpress.com
976.83 руб.
Underwire Lace Push Up Bra and Thong Set Plus Size Bra Set Floral Lingerie Femme Brassiere Sexy Intimates Underwear & Sleepwears
aliexpress.com